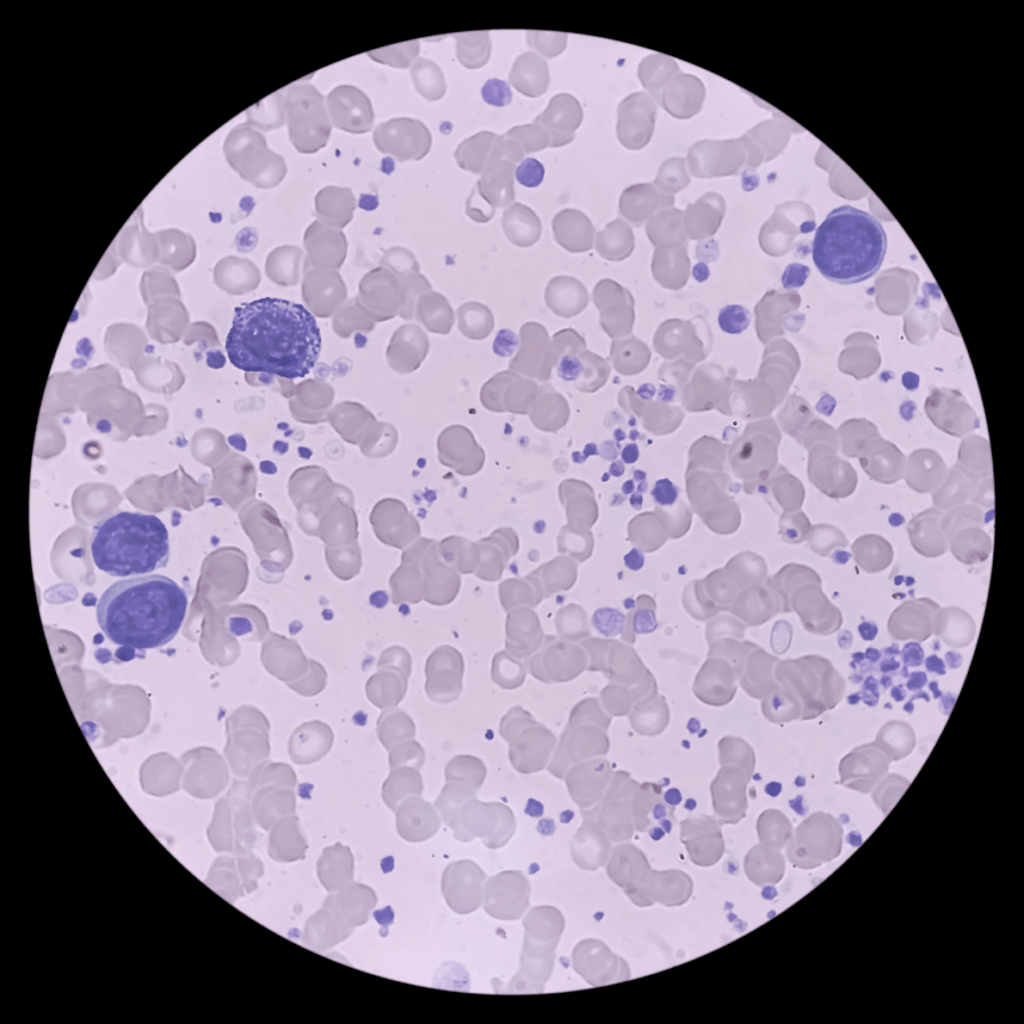

Sussex Cancer Fund: Research Updates 2025
At the Sussex Cancer Fund, we believe that research is key to improving outcomes and quality of life for people affected by cancer. That’s why we actively fund and support local research projects that take discoveries from the lab bench to the bedside.
We work closely with University Hospitals Sussex NHS Foundation Trust, Brighton and Sussex Medical School, the University of Sussex, the University of Brighton, and the Sussex Cancer Research Centre (SCRC) to ensure that our funding supports projects that directly benefit local patients and strengthen the region’s cancer research community.
The following summaries provide a snapshot of where each of our funded research projects currently stands, highlighting the exciting progress being made across Sussex to improve understanding, treatment, and care for people affected by cancer. For a more detailed look at our research updates click here.

Exploring the Gut Microbiome in Anal Cancer Treatment
Formal title: Understanding the gut microbiome in relation to chemoradiotherapy for anal cancer – opportunities for intervention to improve patient outcomes
Lead: Dr Duncan Gilbert / Dr Hamish Sinclair
This project is investigating how bacteria in the gut and tumour tissue influence treatment success and side effects in people with anal cancer. Working within the national PLATO trial, the team has analysed samples from over 400 patients across the UK.
The Sussex-based research aims to reveal whether certain bacteria can predict treatment response or recovery, potentially paving the way for microbiome-targeted therapies. With statistical analysis now underway, results are expected to be presented at the ESTRO 2026 international oncology conference.

Stress and Endometrial Cancer: Linking Mind, Body, and Biology
Formal title: Psychological stress, glucocorticoids, and gynaecological cancers
Lead: Professor Melanie Flint/Sarah Becker
This new project, running until 2026, studies how stress affects women with endometrial (womb) cancer. Patients are providing saliva, blood, hair, and tissue samples to track stress levels alongside treatment progress. Early results show that stress levels are highest around surgery and vary throughout recovery.
The team has also grown “mini-tumours” (organoids) in the lab, revealing that cortisol (stress hormone) can promote tumour growth – while the stress-blocking drug relacorilant can slow it down. This research may lead to new, holistic approaches to treatment that combine psychological and medical care.
Cracking Chemotherapy Resistance in Acute Myeloid Leukaemia (AML)
Formal title: Characterising and targeting chemo-resistant AML cells using a novel in-vitro model of the bone marrow microenvironment
Lead: Dr Eleni Ladikou / PhD student: Imogen Mould
AML is an aggressive blood cancer where treatment resistance remains a major challenge. Using an innovative “Bone Marrow Adhesion System” developed in Sussex, researchers are studying how AML cells hide and survive inside the bone marrow.
Their findings are helping reveal why some drugs stop working and how to improve combinations such as venetoclax and azacitidine. This project not only contributes to global AML research but also strengthens local expertise, ensuring Sussex patients benefit from cutting-edge studies.

Decoding Myeloma: The Hidden Power of Gain(1q)
Formal title: Unravelling the role of gain(1q) in multiple myeloma
Lead: Dr John Jones / PhD student: Abbie Bentley
This three-year project examines how a specific genetic change, known as gain(1q), drives multiple myeloma, a common and currently incurable blood cancer. The research compares patient samples and cell lines to understand why those with gain(1q) respond differently to treatment.
Early progress is promising, with collaborations forming internationally, including with a research team in the USA. All samples have been taken from patients treated in Sussex, underlining how local participation drives global discovery.

Targeting a New Weak Spot in Leukaemia
Formal title: Identifying Novel Treatment Strategies in Acute Myeloid Leukaemia (AML)
Lead: Professor Tim Chevassut / Dr Hyun Park
This PhD project focuses on a protein called TOE1, newly identified as a potential driver of AML. By uncovering how TOE1 interacts with other proteins to help cancer cells grow, researchers have found it influences a pathway that could be targeted by new treatments.
The work has already produced two published papers and earned Dr Park a British Society for Haematology grant and a National Institute for Health and Care Research Fellowship, supporting continued innovation in Sussex.

Helping Patients Cope with Cancer-Related Weight Loss
Formal title: CHANGES2 – Preliminary evaluation of a psychoeducational digital intervention for coping with cancer and weight loss
Lead: Dr Sally Wheelwright
This project is testing a new online tool designed to help patients and carers understand and manage unintentional weight loss during cancer. The interactive website offers practical advice, videos, and psychological support.
Although pilot testing was delayed, the evaluation is now progressing through University Hospitals Sussex, with a focus on improving the patient experience and refining future digital support tools.

Nurses, Pharmacists and Cancer Care – A New Perspective
Formal title: A qualitative exploration of how patients and staff experience nurse and pharmacist-led systemic anti-cancer therapy (SACT) review clinics
Lead: Lisa Barrott
This national PhD study explores how patients feel about being reviewed by specially trained nurses or pharmacists rather than doctors during chemotherapy. It also examines the experience of healthcare staff and the growing role of telephone and virtual consultations.
By analysing these experiences, the study aims to ensure future cancer services remain patient-centred, efficient, and sustainable.

Detecting Brain Metastases Through a Blood Test
Formal title: Developing a BRAIN metastasis extracellular vesicle-based liquid biopsy (BRAINCELL)
Lead: Dr Stephen Robinson
The BRAINCELL study is testing whether blood, urine, or tear samples can reveal secondary brain tumours earlier and more accurately than scans. This collaborative project links the University of Sussex, Royal Marsden Hospital, University of Manchester, and Institute of Cancer Research.
The addition of new research partners has expanded the study’s reach without extra cost, and patient recruitment is now underway, a major step toward developing a simple, non-invasive diagnostic tool for Sussex patients.

Stress and Chronic Lymphocytic Leukaemia (CLL)
Formal title: Investigating the effect of stress hormones on treatment responses in CLL
Lead: Professor Melanie Flint / Emma Kennedy
This upcoming PhD project begins in late 2025 and will study how stress hormones influence treatment response in people with CLL, one of the most common blood cancers. The aim is to understand how managing stress could improve therapy outcomes. Recruitment is due to start at Eastbourne Hospital this autumn.

Bringing More Radiotherapy Trials to Sussex
Formal title: Assessing the impact of additional research radiographer time on patient engagement and recruitment to radiotherapy clinical trials
Lead: Dr Bex Herbertson
Funding from the Sussex Cancer Fund has enabled a new Research Radiographer post to help open more national radiotherapy trials in Sussex, giving local patients access to cutting-edge treatments without having to travel. The goal is to open at least three new trials and recruit more than 30 participants in the first year, demonstrating the value of long-term NHS investment in local research roles.

Understanding Fatigue After Breast Cancer
Formal title: A proof-of-concept investigation of a new model to explain fatigue experienced post breast cancer treatment
Lead: Dr Jeanne Dekerle
Fatigue is one of the most distressing long-term effects of cancer treatment. This study, led by a Sussex-based team, will explore how the brain and body process fatigue, comparing people who have completed breast cancer treatment with healthy participants.
By combining physiological testing, immune profiling, and psychological assessments, this project aims to better understand cancer-related fatigue and lay the groundwork for new ways to manage it.

When Stress Meets Science: Understanding Ovarian Cancer Recurrence
Formal title: The impact of psychological stress on cancer burden and recurrence of tubo-ovarian and primary peritoneal cancers
Lead: Professor Melanie Flint/Sarah Baron
This study explores how stress hormones like cortisol may influence cancer recurrence and immune response. The team has discovered that stress hormones can make ovarian cancer cells more aggressive while weakening immune defences. Early findings suggest that the drug relacorilant could block this process and help prevent recurrence.
Patient recruitment and monitoring are ongoing, with results already gaining international attention – including presentation at the Corcept Conference in San Francisco (2025).

Predicting Cancer-Related Fatigue Before It Starts
Formal title: Identifying patients most at risk of developing cancer-related fatigue
Lead: Professor Sally Wheelwright
Launching in late 2025, this project will analyse data to identify which patients are most likely to experience significant fatigue during cancer treatment. The aim is to allow earlier support and tailored interventions that can make a real difference to wellbeing and recovery.
How You Can Help
Every breakthrough starts with a question – and your support helps Sussex researchers find the answers.
By donating to the Sussex Cancer Fund, you help fund vital research, equipment, and innovation that improve cancer care for local people. Together, we can make sure that discoveries made in Sussex benefit patients today and shape the treatments of tomorrow.
👉 Donate now or find out more about how you can get involved as a fundraiser, volunteer, or business partner.


